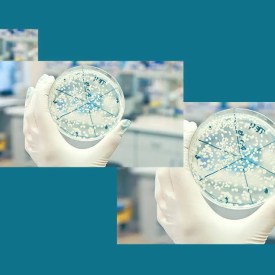

Healthcare
-
-
Events Grind to a Halt in Wisconsin Over Coronavirus
Trying to stay ahead of the virus, cancellations and concerns spread across Wisconsin
-
Gov. Evers Declares Public Health Emergency Over Coronavirus
Two new cases in Dane County, bringing state total to eight
-
Wisconsin Now Has Six Confirmed COVID-19 Cases
Three more people tested positive Wednesday for coronavirus
-
Coronavirus Officially Declared a Global Pandemic
“We are deeply concerned both by the alarming levels of spread and severity and by the alarming levels of inaction,” said a World Health Organization official.
-
Classes Curtailed as Coronavirus Precaution
Update: Many classes moving online, breaks extended, more travel advisories issued
-
GOP’s 2011 Sick Leave Ban Has Outbreak Consequences
Legislature banned cities from requiring employers to offer paid sick leave, even if voters approved.
-
State Has 3rd Coronavirus Case
Officials warn against traveling to Northern California, Florida, New York, Washington State
-
-
Milwaukee Officials Warn Coronavirus is Coming
Mayor urges residents to remain calm, but says he’s concerned virus will spread from Chicago.